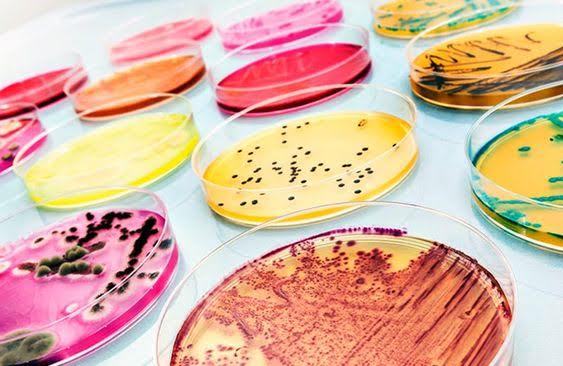

En Laboratorio Jiménez y Medina realizamos análisis de:
- Control microbiológico.
- Control físico-químico.
- Cosméticos de uso general.
- Cosméticos infantiles y contorno de ojos.
- Determinación de poder inhibitorio intrínseco.
- Estudio de eficacia del conservante.
- Challenge test (prueba de eficacia de conservantes).
- Patch test.
- Het Cam.
Nuestro principal objetivo es verificar que el producto final cuente con los requisitos correspondientes y asociados a la normativa vigente, además, analizamos todo tipo de materias primas para la producción cosmética.
Verificamos la higiene en los procesos, la calidad de los productos y la exposición bacteriana. Trabajamos con altos estándares de calidad lo que garantiza la confiabilidad de nuestros resultados.